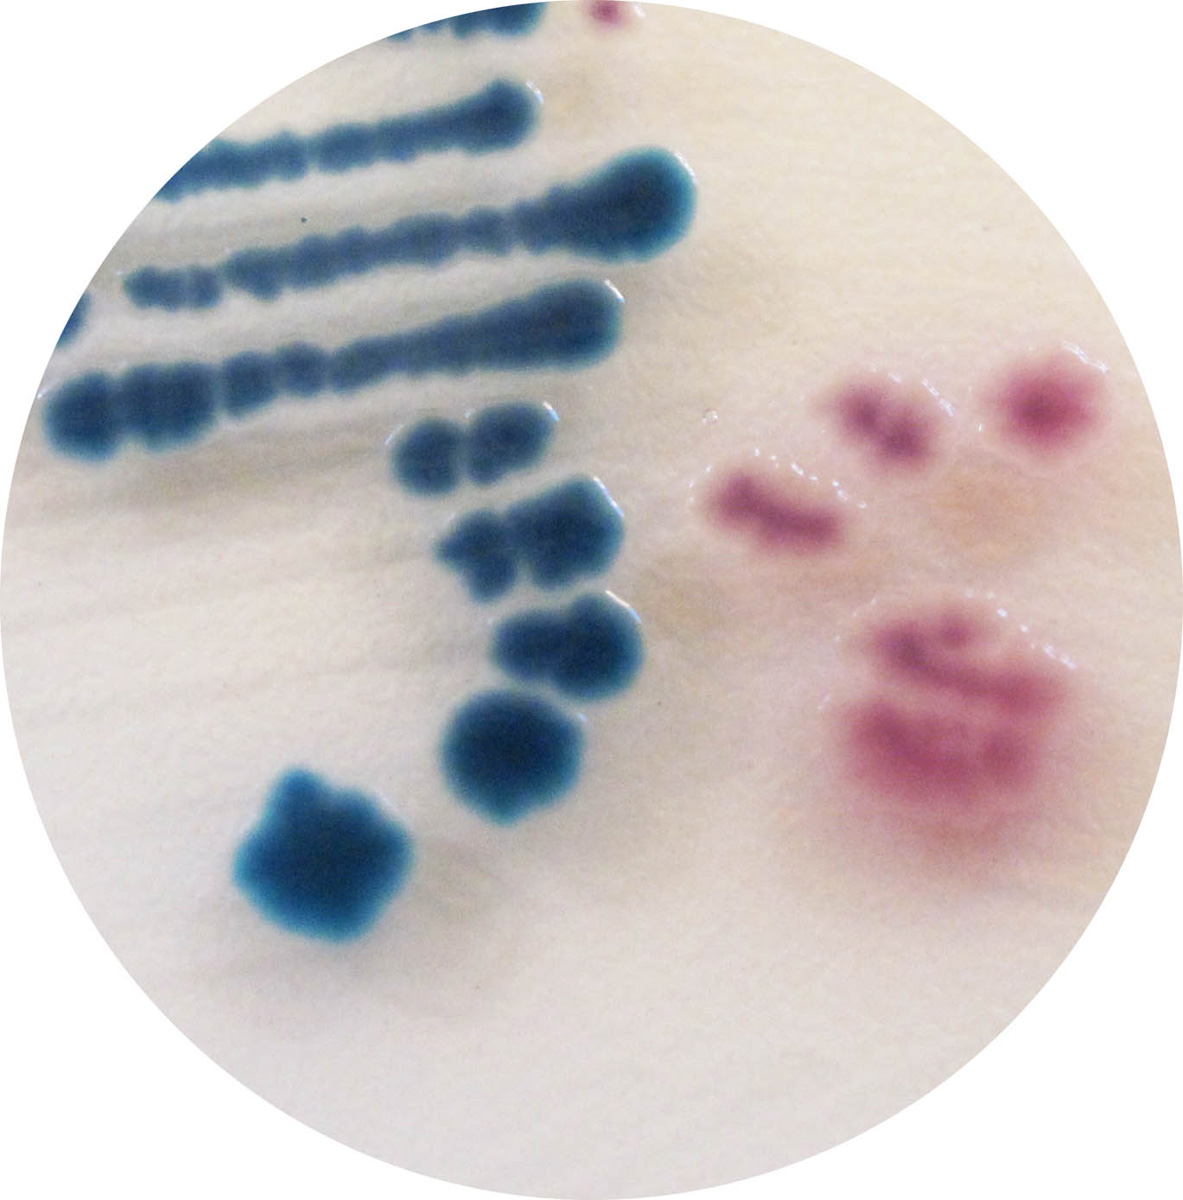

À propos du produit
Milieu chromogène pour la détection et la différenciation directe de Yersinia enterocolitica pathogène.
CHROMAGAR Y.ENTEROCOLITICA

Milieu chromogène pour la détection et la différenciation directe de Yersinia enterocolitica pathogène.